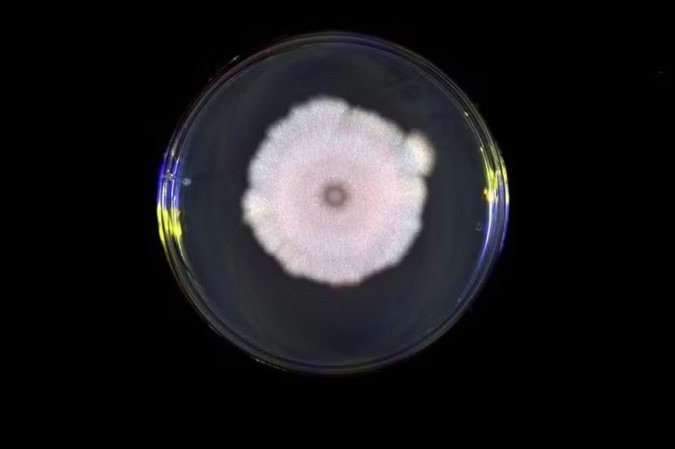

Vírus que infectam bactérias são capazes de “ouvir” sinais químicos emitidos por outros vírus, inclusive até de espécies diferentes, e usar essas informações para decidir se atacam ou permanecem inativos dentro de uma célula. A descoberta, descrita em estudo publicado nesta terça-feira (31/3) na revista Cell por pesquisadores da Universidade de Exeter, revela uma forma sofisticada de comunicação viral que pode influenciar diretamente o sucesso da infecção.
O estudo investigou os vírus bacteriófagos e identificou que eles conseguem detectar sinais químicos produzidos por outros vírus ao seu redor, mesmo quando não pertencem à mesma espécie. Esses sinais fazem parte de um sistema chamado “arbítrio”, no qual os vírus liberam pequenas moléculas, conhecidas como peptídeos, durante o processo de infecção.
A quantidade dessas moléculas no ambiente funciona como um indicador das condições disponíveis. Quando os níveis de peptídeos estão altos, isso sinaliza que há poucas bactérias disponíveis para infectar. Já concentrações baixas indicam um ambiente ainda favorável à multiplicação viral.
Ao invadir uma célula bacteriana, o vírus precisa tomar uma decisão estratégica: seguir pelo caminho, destruindo a célula para liberar novas partículas virais, ou optar pela lisogenia, permanecendo “adormecido” dentro do hospedeiro até que o cenário seja mais favorável.
O estudo mostra que essa escolha pode ser influenciada por sinais externos, inclusive por “mensagens” que não foram emitidas para aquele vírus específico. Na prática, é como se os vírus estivessem espionando conversas químicas alheias para orientar seu comportamento.
Quando a espionagem dá errado
Apesar de sofisticada, essa estratégia pode levar a erros. Ao interpretar sinais de outros vírus, o fago pode tomar decisões equivocadas sobre o ambiente em que está inserido.
Se houver muitas bactérias disponíveis, mas o vírus captar um sinal indicando escassez, ele pode optar por permanecer inativo, perdendo a chance de se multiplicar rapidamente.
Por outro lado, se decidir destruir a célula em um ambiente já saturado, pode produzir novas cópias incapazes de encontrar hospedeiros, sendo eliminadas no ambiente.
O estudo também aponta que essa “comunicação” não é necessariamente cooperativa. Em alguns casos, pode beneficiar o vírus que emite o sinal, mesmo que prejudique outros.
Quando um vírus já está em estado dormente dentro de uma bactéria, ele pode se favorecer se outro vírus, ao detectar seus sinais, também optar por não destruir a célula hospedeira.
“Isso pode beneficiar o vírus que enviou o sinal, pois impede que outro vírus mate as células, mas pode ter um custo para o vírus que responde“, explica Robyn Manley, autora do estudo. “Em outras palavras, a comunicação viral não é apenas cooperação. Às vezes, é manipulação”.
Segundo os pesquisadores, a descoberta amplia a compreensão sobre um campo ainda pouco explorado e pode ter implicações futuras em áreas como microbiologia, evolução e até no desenvolvimento de terapias baseadas em vírus.

Ciência e Saúde
Ciência e Saúde
Ciência e Saúde
Ciência e Saúde